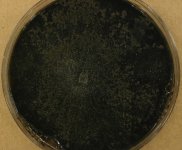

Search Details
| UAMH Number: | 11016 |
|---|---|
| Species Name: | Leptographium longiclavatum |
| Type: | |
| Synonyms: | |
| Taxonomy: | FUNGI Ascomycota, Sordariomycetes, Ophiostomatales, Ophiostomataceae |
| Strain History: | Rice, A. (M002-06-05-13-UL01G70) -> UAMH |
| Substrate: | flame-sterilized wood in galleries of mountain pine beetle (Dendroctonus ponderosae) in Pinus contorta | Location: | CANADA Alberta, Canmore, Harvie Heights (GEO: 51.124,-115.387) |
| Isolator: | A. Rice |
| Isolation Date: | 2008-02-01 |
| Date Received: | 2009-03-30 |
| Characters: | BIODIVERSITY mountain pine beetle genomics project - // MOLECULAR SYSTEMATICS comparative phylogeography - Roe AD, Rice AV, Coltman DW, Cooke JEK, Sperling FAH, Molecular Ecology 20: 584-600, 2011 // MOLECULAR SYSTEMATICS ITS genotype haplotype LI1 - fide A. Roe // MOLECULAR SYSTEMATICS multilocus species identification and DNA barcoding - Roe AD, Rice AV, Bromilow SE, Cooke JEK, Sperling FAH, Mol Ecol Res 10:946-959, 2010 // MOLECULAR SYSTEMATICS spatial community structure of mountain pine beetle fungal symbionts - Roe AD, James PMA, Rice AV, Cooke JEK, Sperling FAH, Microb Ecol 62:347-360, 2011 (Click for publications citing UAMH 11016) |
| Compounds: | |
| Cross Reference: | |
| Collections: | Living Strains; Dried Herbarium Material |
| Pathogenic Potential: | Human: no | Animal: no | Plant: yes |
| Biosafety Risk Group: | RG1 (check the PHAC ePATHogen Risk Group Database for updates) |
| Regulatory Requirements: | No restrictions for Canadian requesters. International requesters must provide all legally required importation documentation prior to shipment. Plant pathogenicity status may be verified by using the USDA Agricultural Research Service (ARS) Fungal Database |
| MycoBank ID: | 356686 |
| Sequences: | >UAMH11016_GU370148_actin GGTGTTGTCACCAACTGGGACGACATGGAGAAGATTTGGCACCACACCTTCTACAACGAGCTGCGTGTGGCTCCCGAGGAGCACCCCATCCTGCTCACGGAGGCTCCCATCAACCCCAAGTCCAACCGTGAGAAGATGACGCAGATTGTGTTCGAGACCTTCAACGCACCGGCCTTCTACGTCAACATCCAGGCCGTGCTGTCCCTGTACGCATCTGGTCGTACCACTGGTATCGTTTTGGACTCTGGTGATGGTGTCACTCACGTCGTGCCCATCTACGAAGGTTTCGCTCTGCCGCACGCCATTGCACGTGTCGACATGGCTGGCCGTGATTTGACCGACTACCTGATGAAGATCCTGGCCGAGCGCGGTTACTCCTTCTCCACCACTGCCGAGCGCGAAATCGTCCGTGACATCAAGGAGAAGCTCTGCTACGTCGCTCTGGACTTTGAGCAGGAGATCCAGACGGCTGCCCAGAGCTCCAGCCTGGAGAAGTCATACGAGCTTCCGGACGGTCAGGTCATCACTATCGGTAACGAGCGGTTCCGCGCCCCCGAGGCTCTGTTCCAGCCGTCCGTACTGGGCCTGGAGAACGGCGGTATCCACGTGACCACCTTCAACTCGATCATGAAGTGCGATGTCGATGTCCGGAAGGACCTGTACGGCAACATTGTCATGGTAAGTGGCGACAGGCAAGGTGGCGAAACGGGTGACACGCACAACGGAACTTTAGCTGACACT >UAMH11016_GU370191_bTub TCGACCCCTGTTTGCTTGTTGTCGTTGTCCCCTCCAGCAAAGGCCTCACCGTCTCTTCGCGATGAAGACGGGGTCGAGATACGGAGACGTGAGACGGACGGAGTCGGGCTTCGGTGCCTGCCCGACATCGTTTGCACTCCGGGTTTTTGACCCGTTTGCTTGATCTTGATCTCGAATCTCGTTGTCGATGGGCCTGGGGAAGGGACATATCTGTGTCCACTTGACTTGCGACCTGGAGACAACGAGAACATTTCTTGATAGCAGAAGTGCCCGCTGCCTTCACGTTGTGTCCTACACAGATTTGAGAATCTCAACTAACGTTTTAACAGGTCCACCTCCAGACTGGCCAATGCGTACGTTTCGCCCTACCCCGAATCAATCGACCCCTACAGGCCCCCAGGCTCCGACGAAACAAACCTTAAACTGACACGGGCTATGGCATAACAGGGTAACCAGATCGGTGCCGCTTTCTGGTAAGTTTTATCTGAGCTATAAATAACGCATCTGGGCAATCTGCTTGAAGTGCCAAATTCTAACCTACTTCACAGGCAGCAGATCTCCAGCGAGCACGGTCTCGACAGCAATGGAGTGTAGGTTTCCGGTTTCGGAAGAGTGTCTATTGTGGTGTATATCATCTAATATGTTCTATCAGGTACAACGGCACGTCTGAGCTCCAGCTGGAGCGTATGAGCGTGTACTTCAACGAGGCCTCGGGCAACAAGTACGTGCCCCGCGCCGTCCTGGTCGATCTCGAGCCCGGCACAATGGATGCTGTGCGCGCCGGTCCTTTCGGACAGCTCTTCCGGCCTGACAACTTCGTTTTCGGCCAGTCGGGTGCCGGCAACAACTGGGC >UAMH11016_GU370234_EF1a GATCTACCAGTGCGGTGGTATCGACAAGCGTACCATCGAGAAGTTCGAGAAGGTTCGTTTTTTCCCTCTTGCTCGCATCTACCCTACCTTCCCTACTGCACACGACACGTCCACTTCCTTTTTCTCATTATCAGAAAGTGGGGTTGGAGGGGCAAATTCTCTTCCCTGTCTTTCTGCCTTGTGGACCCTGAAAATTTTTTGGGCGGTCAGGTTCCGAGCACAATCATCTTGGTGCACGGACCACAACCAGATCTAACCCAACCCCATACTCTATTTACGCCATCTCATCCCCACCTGCTTGCATTTAGATTTGCCGCTAACACCCAAACCAGGAAGCCGCTGAGCTGGGCAAGGGCTCCTTCAAGTACGCATGGGTTCTTGACAAGCTCAAGGCCGAGCGTGAGCGCGGTATCACCATCGATATCGCTCTTTGGAAGTTCGAGACCCCCAAGTACTACGTCACCGTCATTGACGCTCCCGGTCACCGTGACTTCATCAAGAACATGATCACGGGCACGTCGCAGGCCGACTGCGCTATCCTGATCATTGCCGCTGGTACGGGTGAGTTCGAG >UAMH11016_GU370277_LSU CTGCGATAAGTAATGCGAATTGCAGAATTCAGCGAGCCATCGAATCTTTGAACGCACATTGCGCCCGCCAGCATTCTGGCGGGCATGCCTGTCCGAGCGTCATTTCCTCCCTCACGCAGCGCGCCTGCGTGGTGTTGGGGCGTTCTGCGGCCAGGCCTGCGCCCAGCGCAGGCCGCCGCAGCCCCCGAAAGCCAGTGGCGGGCCGGCAGCGGGCTCCGAGCGCAGTAAGCATCACGCCCTCGCTCTGGACGCTCCCGCCTGCGCCCTGCCCCACAGACCGGCAGACGCGAGTCTGCCTCCTTCTCAAGGTTGACCTCGGATCAGGTAGGACTACCCGCTGAACTTAAGCATATCAATAAGCGGAGGAAAAGAAACCAACAGGGATTGCCCCAGTAACGGCGAGTGAAGCGGCAACAGCTCAGATTTGGAATCTGGCCCCCAGGGCCCGAGTTGTAATCTGGAGAGGATGCTTCTGGCGCGGCGCCTTCCGAGTTCCCTGGAACGGGACGCCGGAGAGGGTGAGAGCCCCGTACGGTTGGACGCCTAGCCTTTGTGAAGCTCCTTCGACGAGTCGAGTAGTTTGGGAATGCTGCTCAAAATGGGAGGTAAATTTCTTCTAAAGCTAAATACCGGCCAGAGACCGATAGCGCACAAGTAGAGTGATCGAAAGATGAAAAGCACTTTGAAAAGAGGGTCAAACAGTACGTGAAATTGTTGAAAGGGAAGCGCCCGTGGCCAGACTTGTGCCCCGCGGACCACCCGGCGCCCTCAGCGCCGGTGCACTCCTCGGGGCGCAGGCCAGCATCGGTTTTCCTAGGGGGATAAAGGCGGCGGGAACGTGGCTCCCTCGGGAGTGTTATAGCCCGCCGCGCCATGCCCCTGGGGGGACCGAGGACCGCGCTTCGGCAAGGATGCTGG >UAMH11016_GU370320_UFM GAGCCGACGGCGAGCGCCGCAGCACCTCCAACTGTCCGGGACTGAGCCTGTCCGCCATGTCGGCCGACTGTATGGAGCTGTTAAAAATGATGGTGAAGGAGGCCAGCCCGAGGATGCCGCCTAGAAGTCGGAGTTGCGAAATCGCTCCTTGGGCTACGGCATGGTCTCCCGCTGAAGCCTGCGCCGTTGACAGCATCGTGCCGGCGGACATGAACAGCCCAAACCCAAACCCGAATAGTGTCAGAAACCCGTACATTGGGCCTGCCGGGTAGTCGATTCTGTTGACCGTGGCCAGGAGGCTGGTGCTCACGGCCATGAAAACACACGAAACAACAACCACTGGCGCCGTCCGATTCTTTTTCGCGTTAATCGGGCCCGAGACGAGACAGCCGCCAGCTGTGCCGC |
IMAGES: